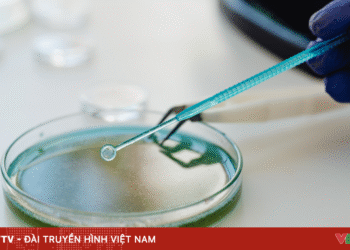
Bộ Y tế yêu cầu xử lý vụ nghi ngộ độc thực phẩm do ăn cá ủ chua tại Đà Nẵng package media 12502733926702112795183 81424765614405286038840.png

TP HCMỨng dụng AI trong sàng lọc ung thư cổ tử cung tại Bệnh viện Hùng Vương trả kết quả trong khoảng 5 phút thay vì chờ đợi 1-2 tuần như xét nghiệm tế bào học, chi phí chỉ bằng khoảng một nửa.
BS.CK2 Huỳnh Xuân Nghiêm, Phó giám đốc Bệnh viện Hùng Vương, tại hội thảo ứng dụng sàng lọc ung thư cổ tử cung bằng trí tuệ nhân tạo (AI) ngày 20/12, cho biết nơi này là một trong những đơn vị đầu tiên tại Việt Nam triển khai kỹ thuật Cervicare AI sau khi Bộ Y tế phê duyệt danh mục kỹ thuật. Hai năm qua, phương pháp này được thí điểm tại một số địa phương nhằm mở rộng sàng lọc cho phụ nữ vùng sâu, vùng xa, trong đó có xã đảo Thạnh An.
Theo ThS.BS Huỳnh Thụy Thảo Quyên, Phó khoa Khám bệnh A, Bệnh viện Hùng Vương, đến nay bệnh viện đã thực hiện sàng lọc bằng AI cho hơn 500 trường hợp, ghi nhận nhiều ưu điểm. AI phân tích hình ảnh cổ tử cung và trả kết quả trong khoảng 5 phút, giúp bệnh nhân được tư vấn và xử trí ngay trong lần khám, thay vì chờ 1-3 tuần như xét nghiệm tế bào học papsmear hay HPV.
Về chi phí, xét nghiệm AI hiện khoảng 320.000 đồng, thấp hơn đáng kể so với pap smear nhúng dịch (khoảng 650.000-700.000 đồng) và chỉ bằng khoảng 1/3 xét nghiệm HPV. Điều này giúp giảm gánh nặng tài chính cho người bệnh khi triển khai sàng lọc ban đầu, vốn có tỷ lệ kết quả bình thường chiếm đa số.
Các nghiên cứu trong và ngoài nước cho thấy hiệu quả sàng lọc của AI tương đương tế bào học, với độ nhạy và độ đặc hiệu cao, đặc biệt trong phát hiện các tổn thương tiền ung thư mức độ nhẹ và nặng. Việc phân tích hình ảnh bằng thuật toán cũng góp phần giảm yếu tố chủ quan so với đọc kết quả hoàn toàn bằng mắt thường.
Tuy nhiên, bác sĩ nhấn mạnh AI không thay thế vai trò của con người. Những trường hợp AI ghi nhận bất thường hoặc còn nghi ngờ sẽ được chuyển sang các bước chẩn đoán tiếp theo như soi cổ tử cung, sinh thiết hoặc làm thêm xét nghiệm chẩn đoán, theo khuyến cáo của Bộ Y tế.

Bác sĩ Bệnh viện Hùng Vương ứng dụng kỹ thuật Cervicare AI tầm soát ung thư cổ tử cung. Ảnh: Yến Phạm
Theo khuyến cáo hiện hành, phụ nữ từ 21 đến 65 tuổi, kể cả người đã tiêm vaccine HPV, vẫn cần sàng lọc ung thư cổ tử cung định kỳ. Trong giai đoạn đầu triển khai, bệnh viện khuyến nghị thực hiện hàng năm; chu kỳ này có thể được điều chỉnh khi có thêm dữ liệu theo dõi dài hạn.
Lãnh đạo Bệnh viện Hùng Vương đánh giá ung thư cổ tử cung vẫn là gánh nặng y tế lớn. Theo số liệu Globocan, mỗi năm Việt Nam ghi nhận khoảng 6.200 ca mắc mới và 2.500 ca tử vong, chủ yếu ở nhóm phụ nữ khó tiếp cận dịch vụ y tế. Việc ứng dụng AI được kỳ vọng giúp tăng độ phủ sàng lọc, đặc biệt tại tuyến cơ sở và vùng khó khăn, góp phần giảm tỷ lệ mắc và tử vong trong những năm tới.
Ung thư cổ tử cung giai đoạn sớm thường không có dấu hiệu rõ ràng, nguyên nhân chủ yếu do nhiễm virus HPV. Các yếu tố nguy cơ khác như quan hệ tình dục sớm, có nhiều bạn tình, bạn tình nhiễm HPV, suy giảm miễn dịch… Do đó, các bác sĩ thường khuyến cáo phụ nữ tiêm chủng vaccine ngừa HPV sớm, kết hợp tầm soát, khám phụ khoa định kỳ 6 tháng một lần để phát hiện bệnh ở giai đoạn sớm.
Lê Phương